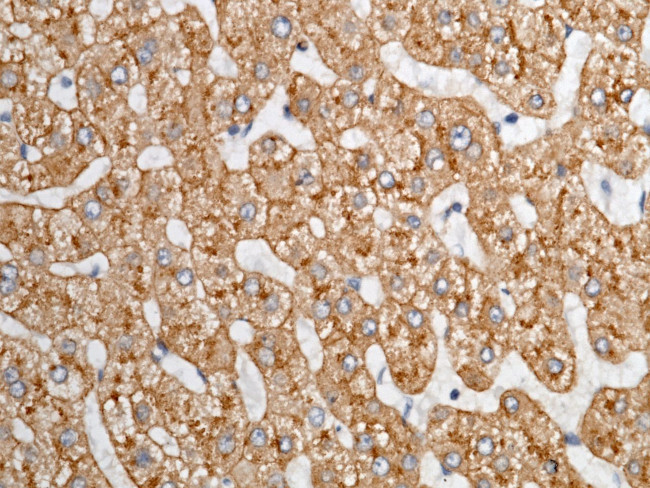
ASGR1 Antibody in Immunohistochemistry (Paraffin) (IHC (P))
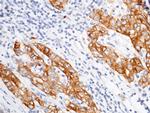
ASGR1 Antibody in Immunohistochemistry (Paraffin) (IHC (P))

Search
Invitrogen
ASGR1 Polyclonal Antibody
{{$productOrderCtrl.translations['antibody.pdp.commerceCard.promotion.promotions']}}
{{$productOrderCtrl.translations['antibody.pdp.commerceCard.promotion.viewpromo']}}
{{$productOrderCtrl.translations['antibody.pdp.commerceCard.promotion.promocode']}}: {{promo.promoCode}} {{promo.promoTitle}} {{promo.promoDescription}}. {{$productOrderCtrl.translations['antibody.pdp.commerceCard.promotion.learnmore']}}
产品信息
PA5-80356
宿主/亚型
分类
类型
抗原
偶联物
形式
浓度
规格
保存条件
运输条件
RRID
产品详细信息
This product is preservative free. It is recommended to add sodium azide to avoid contamination (final concentration 0.05%-0.1%).
This antibody has specificity for Human ASGPR1/ASGR1.
靶标信息
The asialoglycooprotein receptor (ASGPR) is a transmembrane glycoprotein (42 kDa) which mediates binding, internalization and degradation of extracellular glycoproteins that have exposed terminal galactose residues. The receptor is expressed on the surface of the hepatocytes in a polar manner, i. e. it is present on the sinusoidal and lateral plasma membranes but not on the bile canalicular membrane. The mammalian hepatic ASGPR mediate the endocytosis and degradation of serum proteins from which terminal sialic residues have been removed. The rat asialoglycoprotein receptor (ASGPR) consists of three polypeptide subunits: rat hepatic lectin (RHL)-1, RHL-2 and RHL-3. The monoclonal antibody 8D7 recognizes a subunit-specific epitope of RHL-1 of rat ASGPR. The monoclonal antibody 8D7 is cross reactive with human ASGPR.
仅用于科研。不用于诊断过程。未经明确授权不得转售。